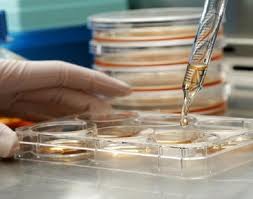
pozyskanie komórek

Kliknięcie przycisku OK, ZGADZAM SIĘ spowoduje aktywację wszystkich zgód koniecznych do bezproblemowego, bezpiecznego i darmowego korzystania z treści portalu. Dane osobowe/pliki cookie mogą być wykorzystywane do personalizacji reklam.Możesz dokonać zmiany ustawień udzielanych zgód, klikając przycisk ZGODY.
Możesz wyrazić zgodę na powyższe cele przetwarzania poprzez kliknięcie w przycisk OK, ZGADZAM SIĘ, możesz również nie wyrażać zgody poprzez wybór ustawień zaawansowanych. W sytuacji braku zgody będziemy przetwarzać dane osobowe w innych celach na innych podstawach prawnych (informacje w tym zakresie dostępne są w naszej polityce prywatności). Poprzez kliknięcie w przycisk ZGODY możesz zarządzać swoimi preferencjami przed wyrażeniem zgody lub odmową udzielenia zgody. Cele przetwarzania Twoich danych bez konieczności uzyskania Twojej zgody w oparciu o uzasadniony interes dr Paradowska Klinika Medycyny Estetycznej Kraków oraz informacje o możliwości sprzeciwienia się takiemu przetwarzaniu znajdziesz w polityce prywatności. Cele przetwarzania Twoich danych bez konieczności uzyskania Twojej zgody w oparciu o uzasadniony interes Zaufanych dr Paradowska Klinika Medycyny Estetycznej Kraków oraz możliwość sprzeciwienia się takiemu przetwarzaniu znajdziesz w ustawieniach zaawansowanych.
Zgoda jest dobrowolna i możesz ją w dowolnym momencie wycofać, zgoda będzie też podstawą przekazywania danych do naszych Zaufanych Partnerów z siedzibą w państwach trzecich (poza Europejskim Obszarem Gospodarczym).
Ponadto masz prawo żądania dostępu, sprostowania, usunięcia lub ograniczenia przetwarzania danych, a także złożenia skargi do Prezesa Urzędu Ochrony Danych Osobowych. W polityce prywatności znajdziesz informacje jak wykonać swoje prawa. Szczegółowe informacje na temat przetwarzania Twoich danych znajdują się w polityce prywatności.
Administratorem tych danych jesteśmy my, czyli dr Paradowska Klinika Medycyny Estetycznej Kraków sp. k. z siedzibą w Krakowie.
Stosowanie plików cookies i innych technologii
Wraz z partnerami stosujemy pliki cookies (tzw. ciasteczka) i inne pokrewne technologie, które mają na celu:
- Zapewnienie bezpieczeństwa podczas korzystania z naszych stron
- Ulepszenie świadczonych przez nas usług poprzez wykorzystanie danych w celach analitycznych i statystycznych
- Poznanie Twoich preferencji na podstawie sposobu korzystania z naszych serwisów
- Wyświetlanie spersonalizowanych reklam, które odpowiadają Twoim zainteresowaniom
Zakres wykorzystywania plików cookies możesz określić w ustawieniach Twojej przeglądarki. Bez wprowadzenia zmian ustawień, informacje w plikach cookies mogą być zapisywane w pamięci Twojego urządzenia. Więcej szczegółów znajdziesz w Polityce cookies.